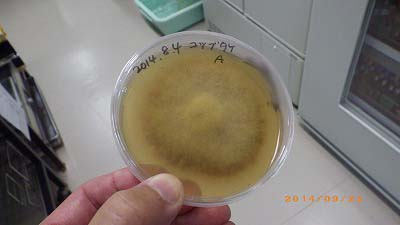
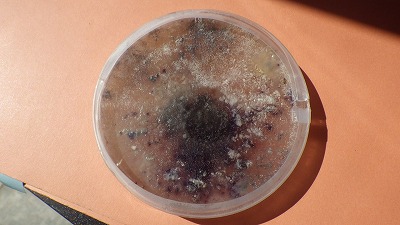

子実体を培養する。
|
|
■ 子実体(きのこ)の菌糸を伸ばす。 |
まずはこの写真を見て頂きたい。 |
 |
.jpg) |
これは何だかお分かりでしょうか? 一般の方には、サッパリ解らないと思います。
樹木医でもほとんどの人が解らないでしょう。 しかし、ヒントを貰えば・・・樹木医ならかなりの人が解ります。
『根っこに見えるでしょ。 根っこのような状態でしょう。』
解る人はこのヒントで解ります。 培地上にあるので、これは菌糸です。 その菌糸が根っこの状態に見えるのは・・・・
そうです。 これが 『根状菌糸束』 と呼ばれるものです。
これは、ナラタケモドキの根状菌糸束です。 ・・・・と、ここで知識のある方は疑問に思うでしょう。
『根状菌糸束が出来るのは、ナラタケでナラタケモドキは作らないのでは?』 と。
当然、そう考えるはずです。 そのように教科書に書いてあるからです。 (※緑化樹木腐朽病害ハンドブックP18参照。)
しかし、それは自然界での話で、このような人工的な培地上では、ナラタケモドキも根状菌糸束を作るのです。
|
| ■ この技術を取得したい! |
初めてこれを見た時に考えた。
『この技術を得れば、実際の現場で確実な診断が出来るんじゃないの? 枯れた樹木の木部などを持ち帰り、それを培養してこの状態になれば、それってならたけ病(ならたけもどき病)を、断定診断できるんじゃないの?』
そう考えて、これを持って来た人に質問してみた。 やはりか。 簡単では無いけど、可能だという。
ふむふむ。そういう事なら、この技術を取得するのも良いだろう。
|
|
|
| ■ 見よう見真似でやってみる! |
とにかくやってみよう! 見よう見真似で実際にやてみた!
|
.jpg) |
.jpg) |
| ナラタケモドキの子実体(きのこ)を用意します。 |
なんだかよく解らないけど、とにかく培地上においてみた。 |
※樹木医同期へ:この子実体は、あの研修のとき、木○根橋で採取したものです。 (^_^;)
|
|
さて、どうなったでしょう・・・・。 って、こんなに簡単な方法で上手く行くわけありません・・・・。
|
|
 |
バクテリアが繁殖しまくり、コンタミしまくり!です。
ぐちゃぐちゃ! (^_^;)
|
|
う〜ん。 これはイカン。 さてさて、どうしたものか。 ここはひとつ専門家に素直に聞いてみよう!
『ふんふん、なるほど、その方法ではコンタミしてぐちゃぐちゃでしょうね。想像が付きますよ。 まずは新鮮な子実体を手に入れなさい。』
そこである人に、『新鮮なモドキを送れ〜!』 と連絡してみた。 ところ・・・ かなりの苦労があったようだが、H氏はちゃんと送ってくれた。
感謝! (^^♪
(※H氏とはFB上での交流のみで、実はまだ逢った事がない。 ただ、絶対にお会いしたい一人である。)
|
|
|
|
|
■ 基本を教わる。 |
|
|
|
 |
.jpg) |
|
こちらがH氏がおくってくれたナラタケモドキ。
|
こちらは練習用に用意したコツブタケ。
|
|
培地作成の基本、培地の種類、バクテリアの抑え方などを教わる。 ・・・う〜ん、全く知らない事ばかりだ・・・ものすごく特した気分です。 (^^♪ |
|
.jpg) |
.jpg) |
|
|
|
.jpg) |
まずはコツブタケで練習をします。
コツブタケは大きいので、扱いが良く、雑菌が入りにくいそうです。
これが上手くいくと、次の2枚の写真のようになるそうです。 |
|
|
|
|
.jpg) |
|
これがコツブタケの’培養菌そう’です。 見る人がみたら、コツブタケにしか見えないそうなのですが、・・・私にはまだよく解りません。 (汗)
|
|
■ そして自分でやる! |
|
『なんだか簡単そうに書いてるけど、実際は器材も必要だし、シロートには無理なんじゃないの?』
という声が聞こえてきそうです。 確かにある程度の器材は必要です。 しかし、高価な器材はなくても何とかなります。
オートクレーブ(高圧蒸気滅菌器)は、圧力鍋で代用します。 クリーンベンチは、キャンプ用のガスバーナーで代用します。
お金なんてかけなくても何とかなります。 ただやり難いだけです。
で、自分でやってみた!
|
|
 |
|
でっ、出来たー!\(^o^)/
|
|
ふぅ、なんとかできました。 今回は、子実体からの培養でしたが、次回は被害木からチャレンジしてみたいと思います。
|
|
■ エピローグ。 しかし、偶然に・・・。 |
|
なんとまぁ。 5枚目のこの写真をもう一度見て欲しい。 |
|
だれがどうみても失敗作・・・のはずだった。 → |
|
|
しかし、裏面をみると・・・・
|
|
 |
← 中央の菌糸束がお分かりだろうか・・・? |
|
拡大して切り抜きました。
中央にヒトデ状に拡がる菌糸がお解かりでしょうか? → |
 |
|
|
|
|
なんと最初に自前で作成した、4つの培地のうちの一つが、成功していたのですね。 (^^♪ |
|
|
|
|